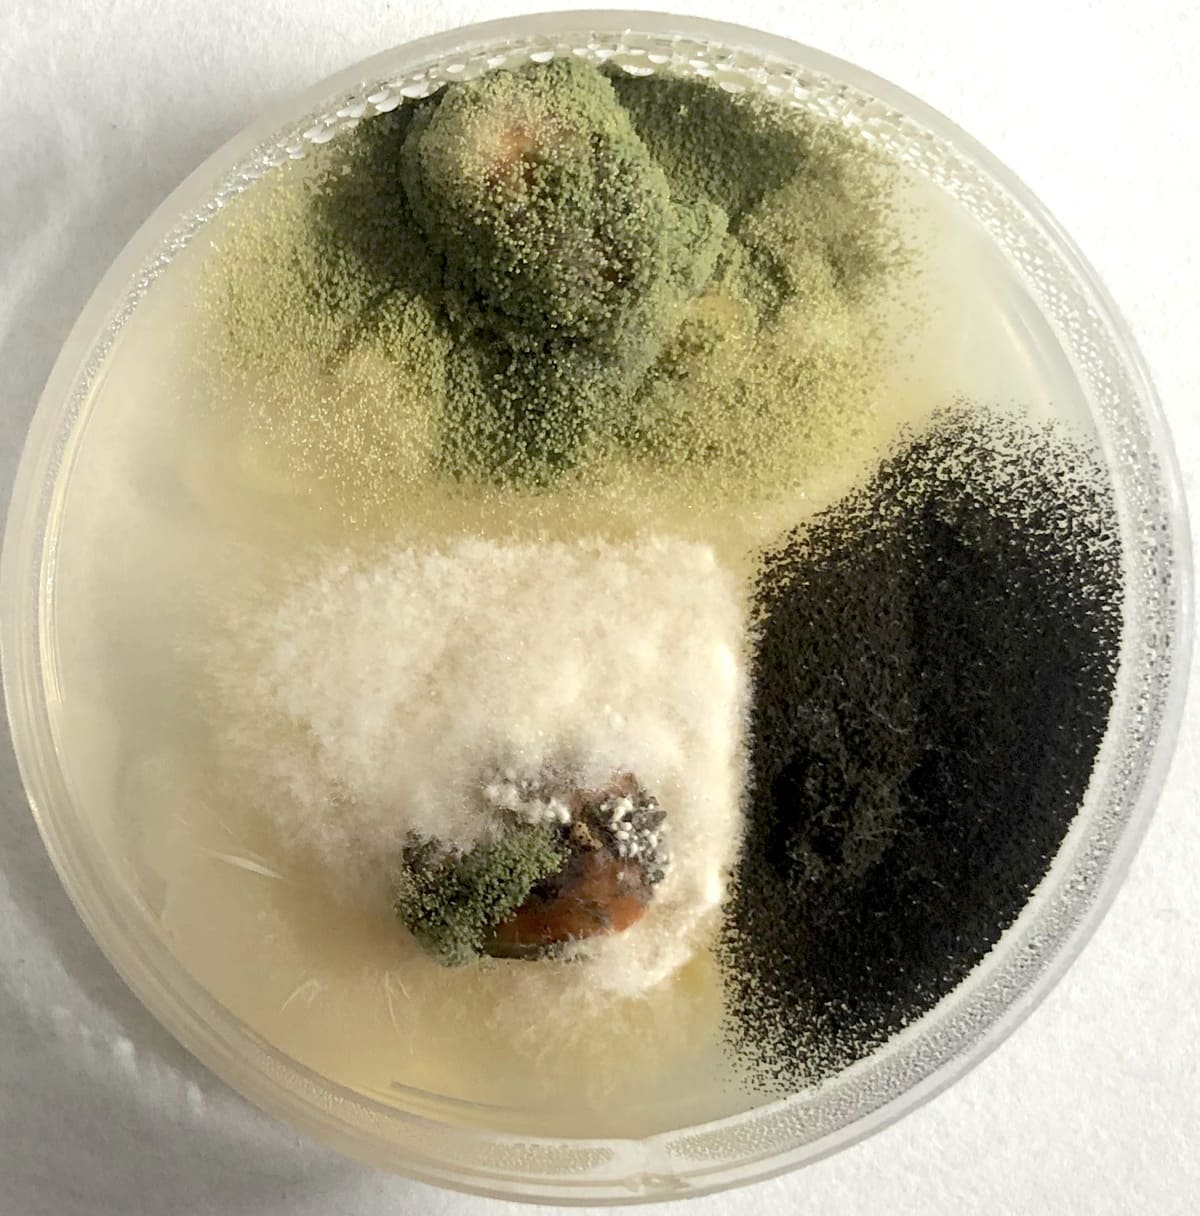

Szántóföldi és üvegházi inokulációs kísérletek
Mit csinálunk: Gabonafélék (kalászosok, kukorica) és olajnövények gombakórokozókkal, köztük a mikotoxin-termelő gombákkal (Aspergillus, Fusarium) szembeni ellenállóságát vizsgáljuk szántóföldi és üvegházi kísérletekben.
Az Ön előnye: Megalapozott fajta/hibrid választás és szelekciós döntések a nemesítés során. A vizsgálatok eredményeként ellenállóbb fajták és hibridek kerülhetnek köztermesztésbe, így csökkentve a termelési kockázatot és a mikotoxin-terhelést, mely végül üzleti eredményt jelent partnereink számára.
Innovatív növényvédelmi technológiák tesztelése
Mit csinálunk: Konvencionális és biológiai növényvédőszerek hatékonyságát teszteljük laboratóriumban, üvegházban és szántóföldön, elsősorban kalászos és kukorica állományokban.
Az Ön előnye: Bizonyítottan hatékony növényvédelmi megoldások, amelyek mérséklik a gombák okozta károkat és javítják a termésbiztonságot.


Növénykórtani diagnosztikai vizsgálatok
Mit csinálunk: Magas színvonalú kutatólaboratóriumi háttérrel azonosítjuk, monitorozzuk és vizsgáljuk a szántóföldi, zöldség- és gyümölcstermesztésben károkat okozó gomba patogéneket.
Az Ön előnye: Gyors és megbízható diagnózis a károsító gombák azonosításához, ami támogatja a célzott beavatkozást és a kockázatcsökkentést.
Mikotoxin-termelő gombatörzsekkel kapcsolatos kutatások
Mit csinálunk: Aspergillus, Fusarium, Alternaria és Penicillium gombanemzetségekhez tartozó törzseket vizsgálunk, különös tekintettel a klímaváltozás e gombapopulációkra kifejtett hatásainak prognosztizálása érdekében.
Az Ön előnye: Tudományos alapú előrejelzések és adatok a mikotoxin-kockázatok kezeléséhez és a hosszú távú termesztési stratégia kialakításához.

Pályázati részvételek, nemzetközi együttműködések, oktatási tevékenység
Mit csinálunk: Cégünk részt vesz pályázatokban, hazai és nemzetközi szakmai fórumokon, konferenciákon, miközben aktív szerepet vállal az oktatásban és a szakmai utánpótlás nevelésében.
Az Ön előnye: Új együttműködések kialakítása, a szakmai hálózat bővítése. Közvetlen hozzáférés a naprakész tudományos és gyakorlati ismeretekhez, valamint az aktív kutatási és fejlesztési környezethez.
Tudománnyal az egészséges növényekért
Az ArtPlanta küldetése a fenntartható növénytermesztés elősegítése a növényi ellenállóképesség fokozásával és hatékony növényvédelmi technológiák kidolgozásával. A laboratóriumi diagnosztikai szolgáltatástól a szántóföldi K+F kísérletekig biztosítunk megbízható, tudományos adatokat, amelyek segítik partnereinket a biztonságos és hatékony termékfejlesztési (nemesítési és növényvédelmi) döntések meghozatalában. Célunk, hogy minden megbízásunk gyakorlati és gazdasági értéket teremtsen, miközben támogatjuk a biztonságos és fenntartható élelmiszerláncot.
